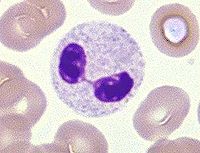

染色质
| A+医学百科 >> 染色质 |
染色质(chromatin)最早是1879年Flemming提出的用以描述核中染色后强烈着色的物质。现在认为染色质是细胞间期细胞核内能被碱性染料染色的物质。染色质的基本化学成分为脱氧核糖核酸核蛋白,它是由DNA、组蛋白、非组蛋白和少量RNA组成的复合物。
目录 |
基本简介
人体内各种细胞,虽然大小不一,形态各异,功能也不相同,但它们都是生命活动的基本场所,其基本结构是一样的,细胞是由细胞核、细胞质和细胞膜组成,在细胞核中,有一种易被碱性染料染上颜色的物质,叫做染色质。其在细胞的有丝分裂期螺旋化形成染色体。它是由脱氧核糖核酸(DNA)和组蛋白组成。是 调节生物体新陈代谢、遗传和变异的物质基础。
每一物种都有特定的染色体。其数目及形态特征在—般情况下是相当稳定的,每条染色体上有许多按顺序排列的遗传物质叫做基因,遗传是由基因控制的,人体细胞染色体共46条。可配成 23对。其中22
对为常染色体,男女都一样。另1对为性染色体。 男女的性染色体有差别。女性的性染色体为二个大小形状相同的x染色体。男性的性染色体则只有一条x染色体,另外还有一条较小的Y染色体,性染色体是决定性别的物质基础,人体细胞每一对成双的染色体叫同源染色体,其中一条来自父亲,一条来自母亲。
间期细胞核内能被碱性染料染色的物质,是遗传物质存在形式。染色质的基本化学成分为脱氧核糖核酸核蛋白,它是由DNA、组蛋白、非组蛋白和少量RNA组成的复合物。其中DNA与组蛋白的重量比例固定,为1∶1,非组蛋白和RNA的比例变化较大。核小体是染色质包装的基本单位。在间期核中,染色质以两种状态存在,有的伸展开呈透明状态,称为常染色质(euchromatin),另一种卷曲凝缩,称为异染色质(heterochromatin)。染色质是一种动态结构。其形态随细胞周期之不同发生变化,进入有丝分裂时,染色质高度螺旋、折叠形成凝集的染色体。
用于化学分析的原核细胞的染色质含裸露的DNA,也就是不与其他类分子相连。而真核细胞染色质却复杂得多,由四类分子组成:即DNA,RNA,组蛋白(富有赖氨酸和精氨酸的低分子量碱性蛋白,至少有五种不同类型)和非组蛋白(酸性)。DNA和组蛋白的比例接近于1:1。
染色质组成物质介绍
染色质主要是由DNA和蛋白质组成的复合物
DNA介绍
细胞中编码和控制的信息是与DNA分子紧密地联系在一起的。DNA与染色质有着重大联系。DNA是一种高分子聚合物,即由重复单位构成的大分子。每一单位都由三种较小分子组成,它们彼此结合形成核苷酸。碱基共有四种:胸腺嘧啶(T),胞嘧啶(C),腺嘌呤(A),鸟嘌呤(G)。人的碱基比例 A:T:G:C是29.2:29.4:21.0:20.4,A+T/C+G比例为1.53。在多数来源DNA中,嘌呤的克分子数等于嘧啶的克分子数,即 A+G=T+C,A=T,C=G。DNA分子由两条螺线缠绕的分子链组成。链由糖和磷酸残基交错连接形成。每条链都有一个糖-磷酸主链和由糖部分向内突出的那些碱基。在DNA分子中各个碱基排列成对,D
NA分子整体呈双螺旋形式。脱氧核糖与碱基的特定碳原子连接,大分子中相邻的两个糖分子通过与磷酸形成的磷酸酯键彼此连接。碱基借助于氢键相互连接,使整个分子保持稳定。碱基配对是严格互补的:A与T配对,C与G配对,DNA分子的两条链在整个分子长度内是彼此互补的。
在人的细胞中,DNA 是位于与膜相连的细胞核内,而蛋白质的合成则在细胞质里进行。细胞直接读出的信息是编码RNA分子上的,细胞不能直接阅读染色体DNA上的信息。 DNA中的胸腺嘧啶在RNA中由极为相似的分子尿嘧啶代替。RNA是单链的,与其模板DNA双螺旋中的一条多核苷酸链互补。这些信息最终被编译成特定的结构蛋白或酶蛋白。
DNA是一种具有多种功能的分子。它能够通过复制过程产生自己,细胞每分裂一次DNA便复制一次。它通过转录过程制造三种RNA:信使 RNA(mRNA),转移RNA(tRNA)和核糖体RNA(rRNA)。这三种RNA在细胞质合成蛋白质的一系列过程中行使不同的功能。信使RNA由DNA模板产生,是按一定顺序排列的三联体密码子,因其是被读出的信息而得名。密码是一种三联体,任一mRNA中核苷酸的数目至少应是所要合成的蛋白质中氨基酸数目的三倍。tRNA由好多种,是一类三叶草形状的分子。 tRNA成分中含有一些异常核苷酸,游离端的末端是核苷酸-CCA,中叶的顶部是三个核苷酸一组,构成反密码子(可以用互补方式与mRNA三联体密码子的三个核苷酸配对),是mRNA编码信息的读者。
为了进行转录,DNA 的双螺旋在RNA聚合酶的作用下被拆开。 RNA聚合酶结合于双链DNA,使它解旋和拆开;同时形成RNA,RNA随RNA聚合酶沿DNA的移动而增加长度。当mRNA从DNA中释放出来,由细胞核进入细胞质,附着于一个或几个核糖体上,其信息由相应的tRNA读出。然后,附着于tRNA-CCA末端的氨基酸彼此连接,形成不断加长的蛋白质。当tRNA到达终止密码子(uAA, uAG, uGA)时,这一过程便告结束,合成的蛋白质被释放出来,作为酶或膜以及其他细胞器的结构分子而供细胞使用。
蛋白质
蛋白质是荷兰科学家格里特在1838年发现的。他观察到有生命的东西离开了蛋白质就不能生存。蛋白质是生物体内一种极重要的高分子有机物,占人体干重的54%。蛋白质主要由氨基酸组成,因氨基酸的组合排列不同而组成各种类型的蛋白质。人体中估计有10万种以上的蛋白质。生命是物质运动的高级形式,这种运动方式是通过蛋白质来实现的,所以蛋白质有极其重要的生物学意义。人体的生长、发育、运动、遗传、繁殖等一切生命活动都离不开蛋白质。生命运动需要蛋白质,也离不开蛋白质。人体内的一些
生理活性物质如胺类、神经递质、多肽类激素、抗体、酶、核蛋白以及细胞膜上、血液中起“载体”作用的蛋白都离不开蛋白质,
它对调节生理功能,维持新陈代谢起着极其重要的作用。人体运动系统中肌肉的成分以及肌肉在收缩、作功、完成动作过程中的代谢无不与蛋白质有关,离开了蛋白质,体育锻炼就无从谈起。在生物学中,蛋白质被解释为是由氨基酸借肽键联接起来形成的多肽,然后由多肽连接起来形成的物质。通俗易懂些说,它就是构成人体组织器官的支架和主要物质,在人体生命活动中,起着重要作用,可以说没有蛋白质就没有生命活动的存在。每天的饮食中蛋白质主要存在于瘦肉、蛋类、豆类及鱼类中。蛋白质缺乏:成年人:肌肉消瘦、肌体免疫力下降、贫血,严重者将产生水肿。未成年人:生长发育停滞、贫血、智力发育差,视觉差。蛋白质过量:蛋白质在体内不能贮存,多了肌体无法吸收,过量摄入蛋白质,将会因代谢障碍产生蛋白质中毒甚至于死亡。
对比介绍
染色质、染色体和染色单体的区别
(1)、染色质和染色体的主要成分都是DNA和蛋白质,它们之间的不同,不过是同一物质在细胞分裂间期和分裂期的不同形态表现而已。
染色质出现于间期,呈丝状。它们在核内的螺旋程度不一,螺旋紧密的部分,染色较深,有的螺旋松疏染色较浅,染色质在光镜下呈现颗粒状,不均匀地分布于细胞核中。细胞分裂时染色质细丝
高度螺旋化形成较粗的柱状和杆状等不同的形状。不同生物的
染色体(习惯不称染色质)数目、形态不同,具有种的特异性,而且比较恒定。
(2)、每个染色体一般具有两个臂或一个臂,两臂之间有着丝点(是纺缍丝附着的地方)。细胞分裂间期由于染色体(习惯不称染色质)复制形成由一个共同着丝点连在一起的两个染色单体被称为姐妹染色单体,这时的染色体仍为一条染色体。当细胞进入细胞有丝分裂后期,着丝点一分为二,姐妹染色单体也随着分开,各有了自己的着丝点,这时就不再是染色单体而叫染色体了,随之染色体数目加倍,染色单体消失。
染色体的组成
一个染色体一般呈棍棒状,包含一个着丝点(c)和两个臂(a、 b)。着丝点是纺锤丝附着的地方,少数染色体的着丝点位于一端。一个染色体只有一个着丝点。因此,对染色体计数时就是看着丝点的数目。
染色体的形态
在细胞周期中,染色体的形态有两种,并且通过一定的方式相互转化。A是通常所说的一个染色体。B是经过复制的染色体,包含两个姐妹染色单体,两个姐妹染色单体是完全相同的
,其含有的物质也与A完全相同。B的着丝点分裂后,就变成了两个完全相同的染色体,称之为姐妹染色体。也就是说,染色体复制后至着丝点分裂之前,染色体的个数不变,但包含有染色单体,也仅在这一段时间内有染色单体。
染色体含分子数
A的一个染色体上有一个DNA分子,而B的染色体中含2个DNA分子,分别位于2个染色单体上。随着着丝点分裂,B形成了C中的2个染色体,因而每个染色体只含一个DNA分子。
DNA分子数
要计算细胞中染色体上的DNA分子数:有染色单体时,DNA分子数=染色单体数,没有染色单体时,DNA分子数=染色体数。
种类介绍
染色质的定义
染色体在细胞周期的间期时DNA的螺旋结构松散,呈网状或斑块状不定形物,即染色质。以浓集状态存在者,称异染色质(1~eterochromatin);以分散状态存在者,称常染色质(euchromatin)。常染色质染色较浅且均匀,异染色质染色深。性染色质与性染色体(x染色体和Y染色体)有关,称x染色质和Y染色质。
x染色质
x染色质曾称巴氏小体或x小体,为紧贴细胞核膜内面的团块状结构,直径约1um,染色程度较其他染色质深。其形态不一,常呈三角、半圆、平凸或球形。利用放射自显影技术的研究发现,女性的两条x染色体中有一条DNA复制延迟,称迟复制x。迟复制的x染色体在间期时表现为x染色质。当细胞内有一条以上x染色体时,在间期时除一条x染色体外,其余的x染色体均表现为x染色质,因此间期细胞核中的x染色质数目等于x染色体数减去1。当x染色体结构异常时,x染色质的形态也会有相应的改变。如x等臂染色体时,出现大的x染色质,双着丝粒x染色体时,出现双叶或大的x染色质。
Y 染色质
Y染色质又称Y小体或荧光小体。Y染色体用荧光染料染色后,呈亮暗不一的荧光带,在Y染色体长臂的远侧段呈明亮的荧光区。在问期时Y染色体长臂远侧段的强荧光特性仍然存在,经荧光染色后,呈强荧光亮点,直径为0.25—0.3um,位于细胞核内的任何部位。
|
|||||||||||||||||||||||||||||||||||||||||||||||
|
||||||||||||||||||||||
| 关于“染色质”的留言: | |
|
目前暂无留言 | |
| 添加留言 | |